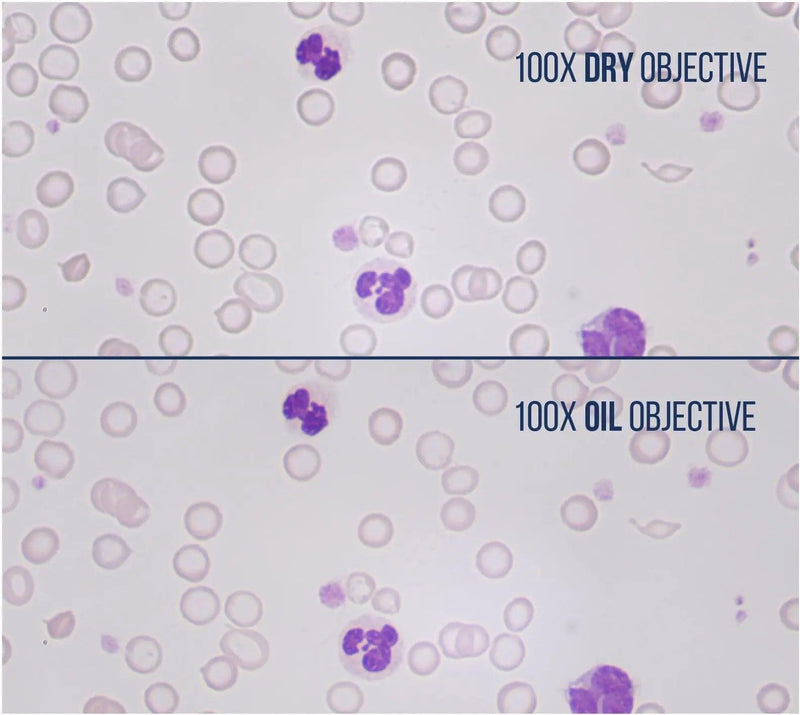

100x Infinity Plan DRY Objective
SKUMSO-100X-IPDR
Product Overview
Never buy immersion oil again, never wipe oil off a slide, never clean oil off your fingers or your microscope stage, never clean oil off of the 100x objective, never drag a 40x objective through the oil, and increase efficiency and speed scanning slides.
Imagine how quickly doctors and techs can scan cytology slides without ever slowing down; plus the satisfaction and relief after so many years of struggling with oil.
This objective installs onto any LW Scientific microscope (i4, Innovation, and Revelation III) and can also be installed onto other microscope brands like Olympus*, Unico, Motic, Labomed, Swift, Accuscope, and Nikon (additional cost of threaded adapter ring, MSP-ADA7-NKOB, required for Nikon e200).
*Does not work with Olympus CX23.
For more information, you can refer to the Specifications and the Manuals.
Support & Resources
Support & Resources
Couldn't load pickup availability

100x Infinity Plan DRY Objective
Recently Viewed

Subscribe to our emails